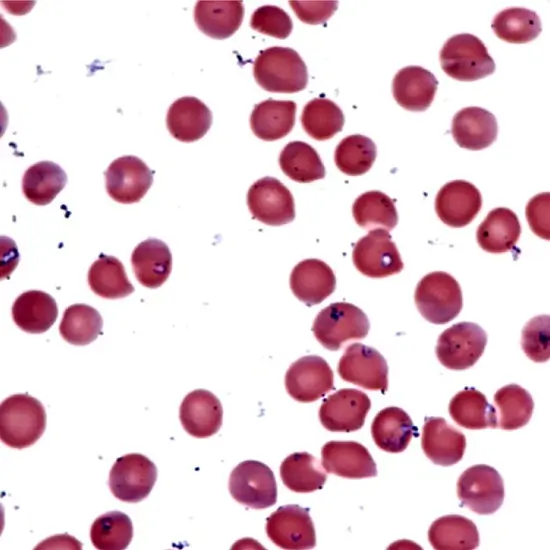

Book Babesia Microti Antibodies, IgG & IgM Appointment Online Near me at the best price in Delhi/NCR from Ganesh Diagnostic. NABL & NABH Accredited Diagnostic centre and Pathology lab in Delhi offering a wide range of Radiology & Pathology tests. Get Free Ambulance & Free Home Sample collection. 24X7 Hour Open. Call Now at 011-47-444-444 to Book your Babesia Microti Antibodies, IgG & IgM
Protozoa are microorganism that belongs to kingdom Protista. They can either be a free living organism or a parasitic one. Babesiosis is a type of zoonotic infection (Came from a non-human to human) that is caused by a parasitic protozoa babesia microti.
Serological test is done to find out the infection if parasitaemia is too low to detect and also when the infection has been already clear either itself or after the treatment. Serology is also applied in the follow up of documented cases of babesiosis or if there is a chance of chronic infection.
>>Blood sample is taken as specimen for this test.
If you are having following given symptoms
Majority of cases of babesiosis are likely to be mild but in some cases the infection can cause serious damage in body or can be deadly especially in older and asplenic patients. In the most serious of the cases, hemolysis the rupture of red blood cells and shock may be seen. Patients may suffer from an enlarged liver or enlargement of spleen.
>>Babesia microti, IgG <1:64
>>Babesia microti, IgM <1:20
The cost of the Babesia microti Antibodies, IgG and IgM test varies from INR 8000 to INR 12000.
| Test Type | Babesia Microti Antibodies, IgG & IgM |
| Includes | Babesia microti Antibodies, IgG and IgM Test (Physician) |
| Preparation | |
| Reporting | Within 24 hours* |
| Test Price |
₹ 5900
|

Early check ups are always better than delayed ones. Safety, precaution & care is depicted from the several health checkups. Here, we present simple & comprehensive health packages for any kind of testing to ensure the early prescribed treatment to safeguard your health.